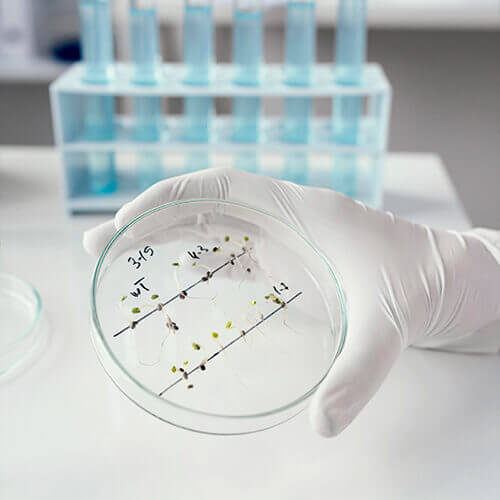

Desenvolvemos soluções especializadas em controle de contaminação ambiental, respaldadas por uma equipe experiente com mais de uma década de atuação no setor.
Localizada estrategicamente em Valinhos/SP, nossa empresa oferece serviços abrangentes de certificação, manutenção preventiva e corretiva de uma variedade de equipamentos essenciais. Estes incluem Fluxo Unidirecional (Laminar), Segurança Biológica, Unidades de Ventilação, Unidades de Descontaminação, Áreas Limpas e Capelas de Exaustão. Nosso compromisso é garantir a qualidade e eficácia no controle de partículas não viáveis, preservando assim a integridade ambiental e a segurança de seus processos.
Com Certifica-Ar, você não apenas obtém um serviço de excelência, mas também a tranquilidade de contar com uma equipe cuja expertise é um diferencial. Invista na experiência que faz a diferença. Invista em Certifica-Ar.

Maximize a eficiência e a performance dos seus sistemas HVAC com nosso serviço de comissionamento. Garanta que seus sistemas de aquecimento, ventilação e ar condicionado estejam operando com máxima eficiência, economizando recursos e otimizando o conforto em seu ambiente.

Conheça a qualidade do ar que você respira. Com nossa contagem precisa de partículas em repouso e em operação, garantimos que seu ambiente esteja livre de contaminantes prejudiciais à saúde, proporcionando um espaço limpo e seguro para você e seus colaboradores.

Mantenha o controle total sobre seu ambiente. Nossos especialistas monitoram e ajustam os gradientes de pressão para garantir a integridade e a segurança dos espaços críticos, assegurando que a contaminação não se propague e mantendo a qualidade do ar em níveis ótimos

Transforme seu ambiente em um espaço confortável e produtivo. Com nossa análise especializada de ruído e iluminação, criamos ambientes que promovem o bem-estar e a eficiência, garantindo que cada detalhe contribua para o seu conforto e desempenho.

Não perca tempo em recuperações demoradas. Com nosso serviço especializado, otimizamos o tempo de recuperação de áreas críticas, minimizando interrupções e maximizando a produtividade, para que você possa voltar às operações rapidamente.

Mantenha o controle total sobre o ambiente. Com nossa monitorização precisa de temperatura e umidade, asseguramos que seu espaço esteja sempre nas condições ideais para operações eficientes e conforto humano, evitando danos a equipamentos e materiais sensíveis.
Oferecemos uma visão clara da qualidade do seu ambiente. Com precisão e expertise, contamos cada partícula, garantindo que sua atmosfera seja livre de ameaças invisíveis. Confie na nossa análise para manter a segurança e a pureza que seu espaço merece. Descubra a verdade por trás da sua qualidade do ar com nossa contagem de partículas viáveis.

Alcance os mais altos padrões de qualidade e conformidade. Nossa equipe certificada classifica seus ambientes de acordo com as normas mais recentes, garantindo que você esteja em total conformidade e operando em níveis de excelência reconhecidos internacionalmente.

Garanta a renovação adequada do ar em seus espaços. Com nossa análise precisa, determinamos o número ideal de trocas de ar para cada área, garantindo ambientes saudáveis e livres de contaminantes, proporcionando segurança e conforto para todos.

Proteja seu ambiente contra impurezas indesejadas. Nossa equipe verifica e mantém a estanqueidade e integridade dos filtros absolutos, garantindo que seu sistema de filtragem opere com máxima eficiência, protegendo contra contaminações e garantindo a pureza do ar.

Maximize a eficiência e a distribuição do ar em seu ambiente. Com nossa análise especializada, otimizamos a velocidade e uniformidade dos fluxos de ar, assegurando que cada canto do seu espaço receba a ventilação adequada para garantir conforto e qualidade do ar.

Alinhe seu ambiente com a excelência. Nossa equipe especializada garante o perfeito paralelismo dos fluxos de ar, minimizando turbulências e garantindo uma distribuição uniforme, essencial para ambientes críticos onde a precisão é fundamental.




Oferecemos uma combinação imbatível de preço acessível e qualidade superior. Enquanto mantemos nossos preços entre os melhores do mercado, nossa mão de obra e produtos continuam a oferecer eficiência e excelência, garantindo que você obtenha o melhor valor pelo seu investimento em controle de contaminação ambiental.

Na Certifica-Ar, nossa agilidade e vontade de resolver problemas são nossos maiores diferenciais. Não apenas diagnosticamos e identificamos questões rapidamente, mas também nos empenhamos para oferecer soluções eficazes de forma ágil. Sua tranquilidade e satisfação são nossa prioridade máxima.

Conte com uma equipe com mais de uma década de experiência no mercado, dedicada a oferecer serviços de comissionamento de HVAC, contagem precisa de partículas, manutenção de gradientes de pressão e muito mais. Nossa expertise comprovada assegura que cada projeto seja conduzido com eficiência e profissionalismo, resultando em ambientes limpos, seguros e em conformidade com as normas vigentes.
Rua Antônio Raposo Tavares, nº 202 - Macuco
Valinhos, SP. CEP 13.279-390